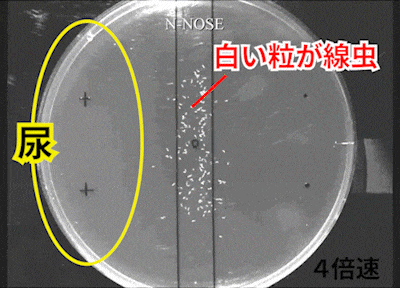
がん患者の尿の場合

多くの医療機関や企業に選ばれています。
医療機関でも導入されている商品です。
がんリスク検査です。
2024年には、2万人以上を対象とした大規模臨床研究の結果も公開されました。
今後も継続的な研究・臨床データの蓄積に努めてまいります。





線虫は離れる
線虫が近づく
※がん種の特定はできません。
※N-NOSEは、採尿時のがんのリスクを評価するものであり、がんの診断を行う検査ではありません。
検査結果をご確認いただいた後、ご自身の健康状態について不安な点がある場合は、医師にご相談ください。

















線虫研究の第一人者として国際的に知られる研究者。
その功績は、国立病院や大学との共同研究に基づき、多数の論文・臨床研究で裏付けられています。

N-NOSEはステージ0や1のがんのリスクを判定することができる世界初のサービスです。
これまでのがん検査は体の異変があり、病院で受けることが当たり前でしたが、
N-NOSEは未病の段階でがんのリスクを判定することができるのです。
しかも、ご自宅で自分自身でそれを顕在化することができます。
リスクが低ければ、家族も自分も安心することができます。
もしリスクが高くても、健康に気を付けたり、より精密な検査を受けたりと、
早い段階で対処ができ、その後の人生を選択することができます。
N-NOSEはすべての人の人生を豊かにします。
今後、医療の発展により、ガンが発症する前に直せるようになったら、N-NOSEと医療で、
私たちは全世界の命を救うことができるのです。
私たちが作るのは、 がんを怖れない世界 、そんな未来です。


| 1997年 3月 |
東京大学大学院理学系研究科生物化学専攻
修士課程 修了 |
|---|---|
| 1998年 4月 |
東京大学大学院理学系研究科生物化学専攻
博士課程 修了 |
| 2000年 3月 | 東大大学院在籍時にNatureに論文を掲載 |
| 2001年 3月 |
東京大学大学院理学系研究科生物化学専攻
博士課程 修了 博士(理学) |
| 2001年 4月 |
日本学術振興会 東京大学遺伝子実験施設
特別研究員 |
| 2004年 4月 |
京都大学大学院生命科学研究科
ボスドク研究員 |
| 2005年 1月 |
九州大学大学院理学研究院 生物科部門 助教 |
| 2016年 8月 |
HIROTSUバイオサイエンス設立
代表取締役社長(現任) |
| 2016年 9月 | ナイスステップ研究者(文部科学省)受賞 |
| 2018年 4月 | Adjunct associate professor,QUT(Australia) |

受検できますか?
現在、薬による検査への影響について、臨床研究では検証できておりません。
「体調がすぐれないとき」「感染症に罹っているとき」などで服薬をされている場合は、受検を避けていただき、体調が整ってから受検してください。
これまでの臨床研究で、判定に影響を及ぼした薬の報告はございませんが、薬による影響がないとは断定できません。
以上のことをご承知のうえ、受検いただくようお願いいたします。
なお、サプリメントによって判定が影響を受けたという報告はございません。
妊娠中は検査をお控えください。
出産後、体調が回復されましたら受検いただけます。
N-NOSEは医療費控除の対象ではありません。(医療機関で受検した場合も同様)
また、検査料金は健康保険適用外で自己負担となります。N-NOSEは医療費控除の対象ではありません。(医療機関で受検した場合も同様)
検体提出後、通常約4週間(申込み状況によっては6週間ほど)でマイページに反映され、【ご登録のメールアドレスへ通知】いたします。
また、書面有のキットを購入されたお客様は、結果通知メール送信後、7営業日以内に書面の検査結果報告書を発送いたします。(年末年始等は遅延する場合があります)


N-NOSEはそんなあなたの未来を守ります。
家族のために、自分のために。
信頼できる検査を、自宅から。












